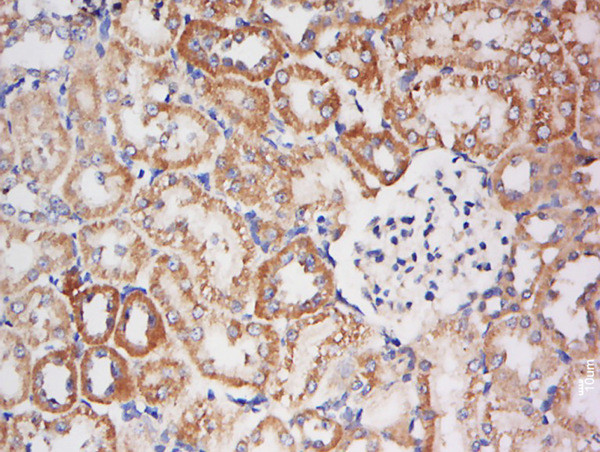
BPNT1 Antibody in Immunohistochemistry (Paraffin) (IHC (P))

Search
Bioss
BPNT1 Polyclonal Antibody
{{$productOrderCtrl.translations['antibody.pdp.commerceCard.promotion.promotions']}}
{{$productOrderCtrl.translations['antibody.pdp.commerceCard.promotion.viewpromo']}}
{{$productOrderCtrl.translations['antibody.pdp.commerceCard.promotion.promocode']}}: {{promo.promoCode}} {{promo.promoTitle}} {{promo.promoDescription}}. {{$productOrderCtrl.translations['antibody.pdp.commerceCard.promotion.learnmore']}}
图: 1 / 4
BPNT1 Antibody (BS-20136R) in IHC (P)




产品信息
BS-20136R
种属反应
宿主/亚型
分类
类型
抗原
偶联物
形式
浓度
规格
纯化类型
保存液
内含物
保存条件
运输条件
靶标信息
BPNT1, also called bisphosphate 3-prime-nucleotidase, or BPntase, is a member of a magnesium-dependent phosphomonoesterase family. Lithium, a major drug used to treat manic depression, acts as an uncompetitive inhibitor of BPntase. The predicted human protein is 92% identical to mouse BPntase. BPntase's physiologic role in nucleotide metabolism may be regulated by inositol signaling pathways. The inhibition of human BPntase may account for lithium-induced nephrotoxicity.
仅用于科研。不用于诊断过程。未经明确授权不得转售。
篇参考文献 (0)
生物信息学
蛋白别名: 3'(2'),5'-bisphosphate nucleotidase 1; 3'-phosphoadenosine 5'-phosphate phosphatase; Bisphosphate 3'-nucleotidase 1; BPntase; BPntase 1; BPntase; lithium-sensitive nucleotidase; inhibited by inositol 1,4-bisphosphate; epididymis luminal protein 20; HsPIP; Inositol-polyphosphate 1-phosphatase; PAP phosphatase; PAP-inositol 1,4-phosphatase; PAP-inositol-1,4-phosphatase; PIP; RnPIP; scHAL2 analogous 3; testicular tissue protein Li 29; unnamed protein product
基因别名: BPNT1; BPntase; HEL20; HsPIP; PIP; Sal3
UniProt ID: (Human) O95861, (Mouse) Q9Z0S1, (Rat) Q9Z1N4
Entrez Gene ID: (Human) 10380, (Mouse) 23827, (Rat) 64473